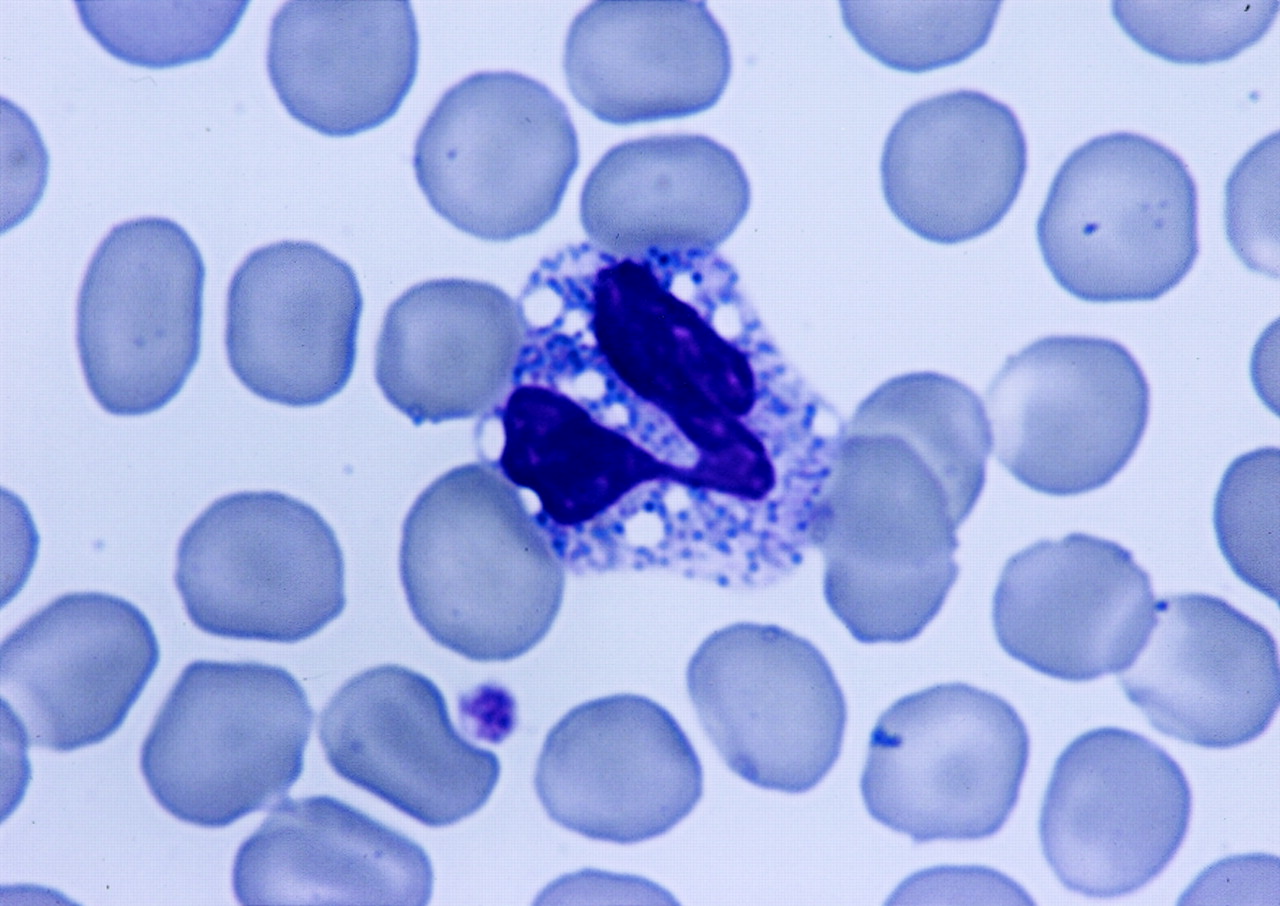

Вакуолизация моноцитов
Консультация по адаптации детей раннего возраста
Являются ли слова сыр и сырник однокоренными
Kiwano стикеры
Аксессуары x trail
Dream it real
Грантовые фонды 2024
Изменения связанные с процессом умирания обусловлены
Тетрадь в клетку с плотной обложкой
Пирожное на заварном тесте
Наполнение кресел
Кухонный гарнитур дуб крафт золотой
Мартен гагарина
Frozen leviathan
Вакуолизация моноцитов 109 фото